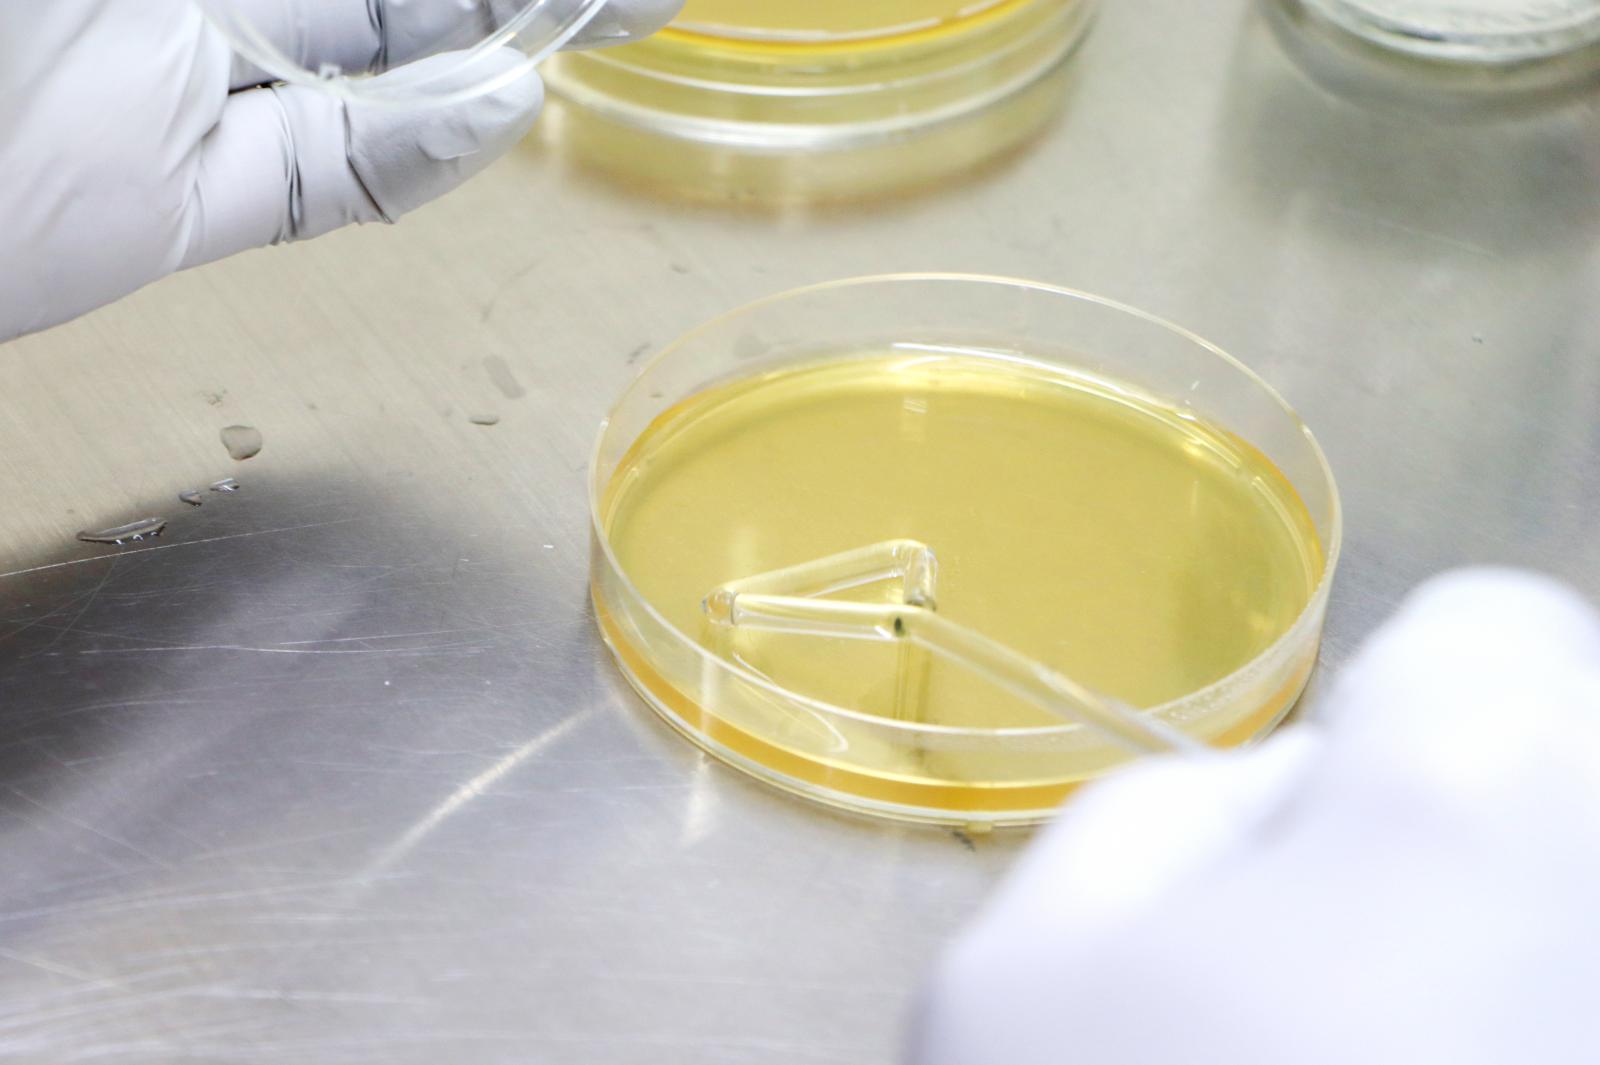

【いつでも青春キャンパス】野生酵母を探索しました!!
シニア大学生の阿部孝志さん(65歳)と伊藤晴美さん(67歳)は、秋田県内の各所から酵母などの発酵微生物を探索し、取得した生物資源を利用して、製品化を目指した発酵食品を試作・提案する研究に取り組んでいます。
8月17日(木)、応用生物科学科食品醸造研究グループの吉川 雄樹 助教[専門:醸造微生物学]の指導の下、秋田市の千秋公園と八郎湖周辺にて、研究材料となる水試料や自然植物を採取し、野生酵母を探索しました。
その後、研究室に戻り、収集した試料から酵母の単離を試みるため、それぞれの栄養寒天培地に懸濁液を塗布する作業などを行いました。今後も酵母の形態を観察したり、遺伝子解析から生物種を特定したりするなど、じっくりと実験を進めていく予定です。
この試料から有用な酵母を探し出し、市販のパン酵母とは異なる特徴のパン作りにチャレンジするのが2人の目標です。「食品業界で勤務した経験を活かし、米粉を使った特徴的なパンを作ってみたい!!」と阿部さん。伊藤さんは「新たな魅力を持った酵母が秋田には存在するのではないか!!どんな酵母がいるのか結果が楽しみ」と話しました。
【生涯学習プログラム『いつでも青春キャンパス』】
65歳以上の方を「シニア大学生」として1年間、本学で受け入れ、在学生と一緒に学習や研究、課外活動に取り組む生涯学習プログラムで、65歳から75歳の15人が学生と共に講義を受けたり、サークル活動に参加したりして、キャンパスライフを満喫しています。
千秋公園の池から水試料を採取
有用な酵母を見つける!!
吉川 雄樹 助教[醸造微生物学]が研究指導
秋田県内各地を駆け回る
マイクロピペットを上手に操作
製パン等に使えるような発酵力のある酵母を期待